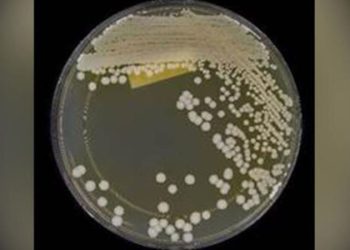
ABD alarmda: İlaca dirençli mantar hastalığı yayılıyor

Sağlık Bakanlığı ne kadar personel alacak? Sağlık Bakanlığı hangi branşlarda personel alacak, başvuru nereden, nasıl yapılır?
Sıhhat Bakanlığı bünyesinde çalışıcak kontratlı işçi alımları yapılacak. Kontratlı işçi alıma dair ilanın Resmi Gazete'de yayınlanmasından sonra iş sahibi olmak ...